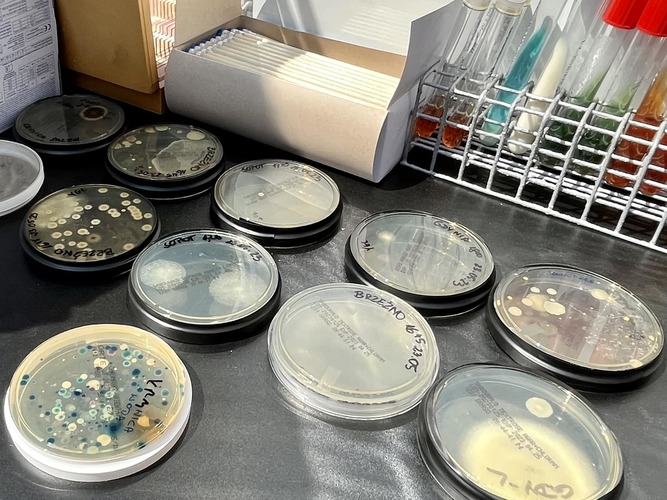

Drugi Piknik Nauki Fahrenheita za nami
31.05.2023
Uczelnie Fahrenheita, czyli Gdański Uniwersytet Medyczny, Politechnika Gdańska i Uniwersytet Gdański, wspólnie z Hevelianum i partnerami, zamieniły w minioną niedzielę Górę Gradową w wyjątkowe, naukowe miasteczko. Piknik, któremu patronował słynny gdański uczony Daniel Fahrenheit, przyciągnął licznie nie tylko pracowników uczelni i ich rodziny, ale również wielu mieszkańców Gdańska. W wydarzeniu udział wzięło ponad 5000 osób. Na gości Pikniku czekała Scena naukowa i Strefa eduzabawy, które obfitowały w warsztaty, konkursy, pokazy i naukowe zagadki.

od lewej: Stanisław Szultka, Paweł Golak, prof. Michał Markuszewski, Monika Chabior, prof. Piotr Stepnowski i prof. Krzysztof Wilde
Tegoroczny Piknik Nauki Fahrenheita upłynął pod hasłem Nauka z klimatem. Organizatorzy nawiązywali do celów zrównoważonego rozwoju zapraszając gości do wspólnej zabawy, doświadczania i odkrywania nauki z innej strony. W lekkiej piknikowej formule była mowa o rzeczach ważnych i bardzo pożytecznych, mających wpływ zarówno na środowisko, jak i dobrostan samego człowieka.
Jednym z głównych punktów na piknikowej mapie była Scena naukowa. O godzinie 11:00 przy akompaniamencie Gdańskiej Orkiestry Akademickiej odbyło się uroczyste otwarcie wydarzenia. Wzięli w nim udział: Monika Chabior, zastępczyni prezydent ds. rozwoju społecznego i równego traktowania, prof. Michał Markuszewski, prorektor ds. nauki Gdańskiego Uniwersytetu Medycznego oraz pełnomocnik Rektora GUMed ds. Uczelni Fahrenheita, prof. Krzysztof Wilde, rektor Politechniki Gdańskiej, prof. Piotr Stepnowski, rektor Uniwersytetu Gdańskiego, Paweł Golak, dyrektor Hevelianum oraz Stanisław Szultka, dyrektor Departamentu Rozwoju Gospodarczego Urzędu Marszałkowskiego Województwa Pomorskiego.

Podczas trwania Pikniku Nauki Fahrenheita na Scenie naukowej można było podziwiać pokaz mody zero waste, na którym ku zachwytom zgromadzonych gości przedstawiciele Uczelni Fahrenheita i Hevelianum prezentowali stroje oraz biżuterię wykonane z niestandardowych materiałów lub ponownie wykorzystanych.
Dużym zainteresowaniem cieszyły się pokazy naukowe przygotowane m.in. przez edukatorów Hevelianum i Heweliuszy Nauki. Na scenie wręczone zostały również Nagrody Uczelni Fahrenheita, a Stanisław Szultka, dyrektor Departamentu Rozwoju Gospodarczego Urzędu Marszałkowskiego Województwa Pomorskiego, osobiście pogratulował laureatom I edycji programu stypendialnego Prezydent Miasta Gdańska im. Daniela Fahrenheita dla doktorantów z zagranicy. Gospodarzami Sceny naukowej byli Aleksandra i Piotr Stanisławscy, autorzy bloga popularnonaukowego Crazy Nauka.

Ważnym punktem na mapie pikniku było Miasteczko naukowe, a w nim 45 namiotów z pokazami, warsztatami i eksperymentami, przygotowanymi przez Gdański Uniwersytet Medyczny, Politechnikę Gdańską i Uniwersytet Gdański. Można było się dowiedzieć m.in. jak stworzyć mózg z rzeczy z odzysku, jak powstają fale i co można zrobić ze zużytymi oponami. Na ochotników czekały doświadczenia z ciekłym azotem, samochodziki napędzane wodorem czy escape room o tematyce medyczno-dietetycznej. Nie zabrakło też stanowiska do bezpłatnych badań profilaktycznych, z których chętnie korzystali piknikowi goście.
Partnerzy wydarzenia zapraszali do udziału w warsztatach ekologicznych w Strefie eduzabawy. Dużym zainteresowaniem cieszyły się zajęcia z samodzielnego tworzenia doniczek z plastikowych odpadów, domowych kosmetyków, eko biżuterii czy piórników ze skrawków materiałów.
Jedną z tegorocznych nowości było Laboratorium Fahrenheita, czyli wyjątkowe połączenie teatru i laboratorium chemicznego, gdzie opowieści o życiu słynnego gdańskiego naukowca były tworzone przy wykorzystaniu chemicznych efektów specjalnych. Przedstawienie było oparte na fragmentach spektaklu Fahrenheit w reż. Michała Derlatki z Teatru Miniatura, a bezpłatne wejściówki rozeszły się w mgnieniu oka.

Dopełnieniem atrakcji Pikniku Nauki Fahrenheita była debata naukowa Nauka Mówi. W równowadze, podczas której zaproszeni goście dyskutowali m.in. o tym, czy ambitne cele zrównoważonego rozwoju są do pogodzenia z naszymi potrzebami oraz na co mamy realny wpływ i gdzie już dziś możemy wprowadzić zmiany. Debatę poprowadziła Aleksandra Stanisławska, dziennikarka naukowa, współtwórczyni CrazyNauka.pl. W debacie udział wzięli: dr Maciej Tankiewicz z Zakładu Toksykologii Środowiska GUMed, prof. Szymon Malinowski z UW, z PG: dr Hanna Staroszczyk i Marcin Jasiukowicz oraz z UG: dr Barbara Kijewska.
wideo: Mateusz Byczkowski/Zespół Promocji UG
fot. GREGMAR, Joanna Śliwińska/GUMed